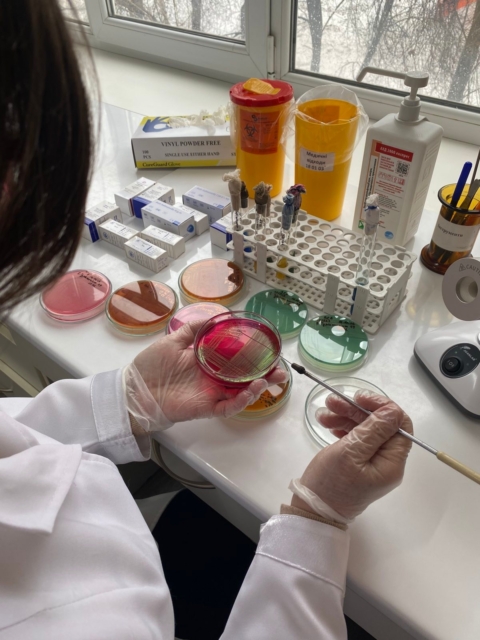
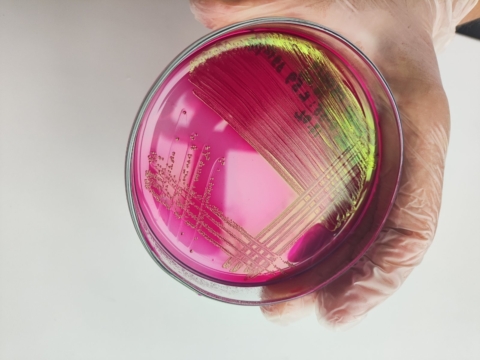

Відбувся черговий тренінг фахівців бактеріологічної лабораторії
18 лютого 2026З метою підтримки функціонування системи менеджменту якості ISO 15189:2022 у Медичній лабораторії 18 лютого 2026 року відбувся черговий тренінг фахівців бактеріологічної лабораторії. Під час тренінгу розбирали важливі елементи роботи аналітичного етапу дослідження патогенних ентеробактерій та дослідження випорожнень на дисбіоз.
Розглянули теоретичну та практичну частину досліджень, зокрема:
– первинний посів – використання диференціально-діагностичних середовищ та морфологічні особливості мікроорганізмів;
– ідентифікація – оцінка біохімічних властивостей та особливості проведення серотипування сальмонел та шигел;
– елементи контролю якості – перевірка кожної серії поживних середовищ на здатність підтримувати ріст цільових мікроорганізмів та пригнічувати супутню флору.
Проведення регулярних тренінгів є робочим інструментом підтримки точності діагностики та запорукою стійкості системи якості лабораторних досліджень у відповідності до вимог державного стандарту ISO 15189:2022.